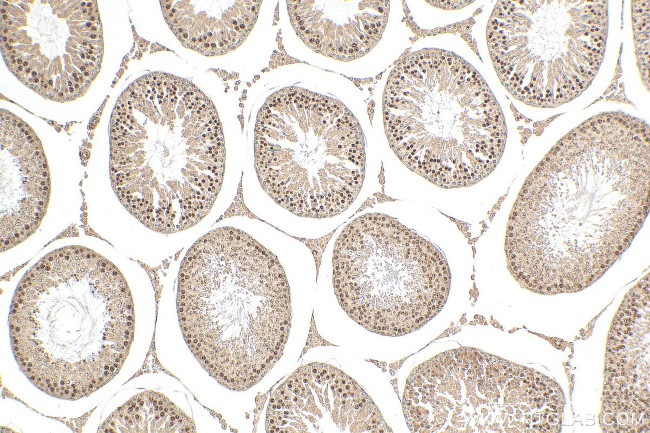
RFX2 Antibody in Immunohistochemistry (Paraffin) (IHC (P))

Search
Proteintech
RFX2 Polyclonal Antibody
{{$productOrderCtrl.translations['antibody.pdp.commerceCard.promotion.promotions']}}
{{$productOrderCtrl.translations['antibody.pdp.commerceCard.promotion.viewpromo']}}
{{$productOrderCtrl.translations['antibody.pdp.commerceCard.promotion.promocode']}}: {{promo.promoCode}} {{promo.promoTitle}} {{promo.promoDescription}}. {{$productOrderCtrl.translations['antibody.pdp.commerceCard.promotion.learnmore']}}
产品信息
12622-1-AP
种属反应
宿主/亚型
分类
类型
抗原
偶联物
形式
浓度
规格
纯化类型
保存液
内含物
保存条件
运输条件
产品详细信息
Sequence of this protein is as follows: VLPKDKLISL CQCDPILRWM RSCDHILYQA LVEILIPDVL RPVPSTLTQA IRNFAKSLEG WLTNAMSDFP QQVIQTKVGV VSAFAQTLRR YTSLNHLAQA ARAVLQNTSQ INQMLSDLNR VDFANVQEQA SWVCQCEESV VQRLEQDFKL TLQQQSSLDQ WASWLDSVVT QVLKQHAGSP SFPKAAQQFL LKWSFYSSMV IRDLTLRSAA SFGSFHLIRL LYDEYMFYLV EHRVAEATGE TPIAVMGEFN DLASLSLTLL DKDDMGDEQR GSEAGPDARS LGEPLVKRER SDPNHSLQGI
靶标信息
This gene is a member of the regulatory factor X gene family, which encodes transcription factors that contain a highly-conserved winged helix DNA binding domain. The protein encoded by this gene is structurally related to regulatory factors X1, X3, X4, and X5. It is a transcriptional activator that can bind DNA as a monomer or as a heterodimer with other RFX family members. This protein can bind to cis elements in the promoter of the IL-5 receptor alpha gene. Two transcript variants encoding different isoforms have been described for this gene, and both variants utilize alternative polyadenylation sites. [provided by RefSeq, Jul 2008].
仅用于科研。不用于诊断过程。未经明确授权不得转售。
篇参考文献 (0)
生物信息学
蛋白别名: DNA-binding protein RFX2; FLJ14226; HLA class II regulatory factor RFX2; Regulatory factor X 2; regulatory factor X, 2 (influences HLA class II expression); trans-acting regulatory factor 2; unnamed protein product
基因别名: 5430432H19Rik; RFX2
UniProt ID: (Human) P48378, (Mouse) P48379, (Rat) B2GV50
Entrez Gene ID: (Human) 5990, (Mouse) 19725, (Rat) 301121